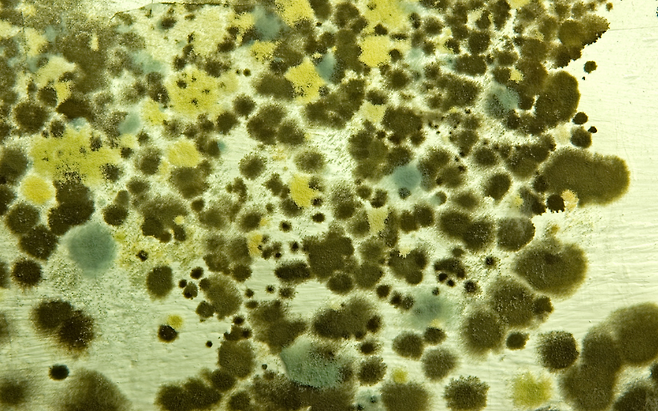

싱크대 배수구에서 올라오는 불쾌한 냄새, 단순 음식찌꺼기 때문이라고 넘어가셨습니까? 거름망을 하루만 방치해도 세균·곰팡이가 뒤엉킨 ‘균막’이 형성돼 석면 먼지 못지않은 미세 입자를 공기 중에 퍼뜨립니다.
설거지 물줄기가 튈 때마다 박테리아 덩어리가 주방 전체로 분사돼 흡입·경구 감염 위험을 만들고, 면역력이 약한 가족에게는 치명적 패혈증까지 부를 수 있습니다. 매일 갈지 않는 거름망 하나가 수명 단축의 도화선이 될 수 있다는 사실을 기억해야 합니다.
균막은 항생제도 뚫지 못합니다

세균과 곰팡이는 거름망 표면에 다당류·단백질을 분비해 방패막 같은 균막을 만듭니다. 이 막은 항생제가 침투하기 어렵고 염소 소독에도 100배 이상 내성을 보여, 일반 세척으로는 거의 제거되지 않습니다.
균막 안에서 레지오넬라·녹농균 같은 병원성 세균이 증식하며, 물줄기에 섞여 폐 깊숙이 침투하면 급성 폐렴을 일으킬 수 있습니다.
미세 에어로졸이 폐까지 직행합니다

설거지 중 물이 거름망에 부딪히면서 직경 5μm 이하의 미세 물방울이 발생합니다. 이 에어로졸에는 균막 조각과 독소가 포함돼 2m 이상 퍼지므로 조리대·식기·호흡기를 동시에 오염시킵니다.
석면 먼지처럼 크기가 작아 코 점막을 지나 폐포까지 도달해 치명적 염증을 유발합니다.
고온·습기가 ‘세균 인큐베이터’가 됩니다
배수구 내부 온도는 설거지 직후 35℃ 안팎으로 유지돼 세균 번식에 최적이며, 기름기·전분이 영양분을 공급해 24시간 만에 세균 수가 1,000배 급증합니다.
여름철에는 곰팡이 포자까지 더해져 암덩어리 같은 독성 복합체를 형성해 호흡기·피부 감염 위험을 폭발적으로 높입니다.
매일 교체·소독만이 안전벨트입니다

음식 찌꺼기는 식사 직후 거름망째 들어 올려 폐기하고, 새 거름망을 끼우기 전 70℃ 이상 뜨거운 물로 배수구를 30초 이상 세척하십시오. 주 1회 배수구에 베이킹소다 한 컵과 식초 반 컵을 부어 거품이 잦을 때까지 반응시키면 균막 초기층을 효과적으로 분해할 수 있습니다.
스테인리스 거름망은 매주 열탕 소독, 플라스틱 거름망은 한 달 사용 후 교체하면 재오염을 막습니다.
싱크대 배수구 거름망을 매일 갈지 않는 작은 귀찮음이 석면 먼지처럼 위험한 균막을 키워 가족의 폐와 장기를 위협합니다.
교체·열탕·소독을 습관화하면 세균 폭탄은 눈에 띄게 줄어듭니다. 오늘 설거지 후 거름망부터 비우고 씻어내는 1분의 실천이 주방 위생과 건강을 지키는 가장 확실한 보험입니다.
Copyright © 뇌생각